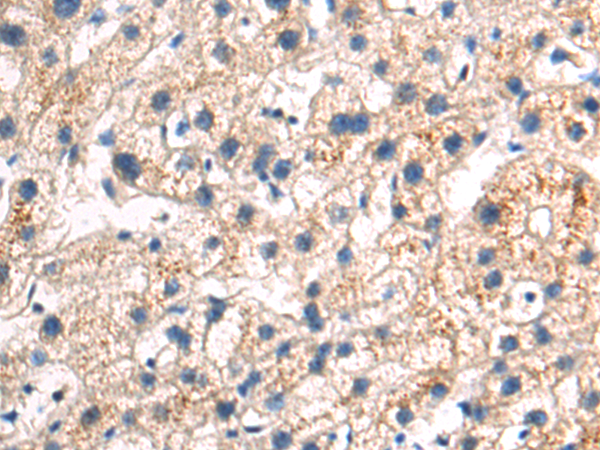

-
分类: 科研抗体货号: P01013别名:应用: IHC反应种属: Human, Mouse
-
分类: 科研抗体货号: P01063别名: GST2; GTA2; GTH2; GSTA2-2应用: IHC反应种属: Human
-
分类: 科研抗体货号: P01007别名: HSN1; LBC1; LCB1; SPT1; SPTI; HSAN1应用: WB,IHC反应种属: Human
-
分类: 科研抗体货号: P01060别名:应用: WB反应种属: Human
-
分类: 科研抗体货号: P01002别名: EPS15R应用: WB,IHC反应种属: Human, Mouse
-
分类: 科研抗体货号: P01057别名: CHGN2; PRO0082; GALNACT2; GALNACT-2应用: IHC反应种属: Human, Mouse
-
分类: 科研抗体货号: P00992别名: IAP应用: IHC反应种属: Human
-
分类: 科研抗体货号: P01051别名: PFKF; PFK-C应用: WB,IHC反应种属: Human, Mouse, Rat
-
分类: 科研抗体货号: P00991别名: BOR; DasraB; MESRGP; BOREALIN应用: WB,IHC反应种属: Human
-
分类: 科研抗体货号: P00990别名: CAD6; KCAD应用: WB,IHC反应种属: Human, Mouse, Rat

鄂公网安备42018502007531号
鄂公网安备42018502007531号

